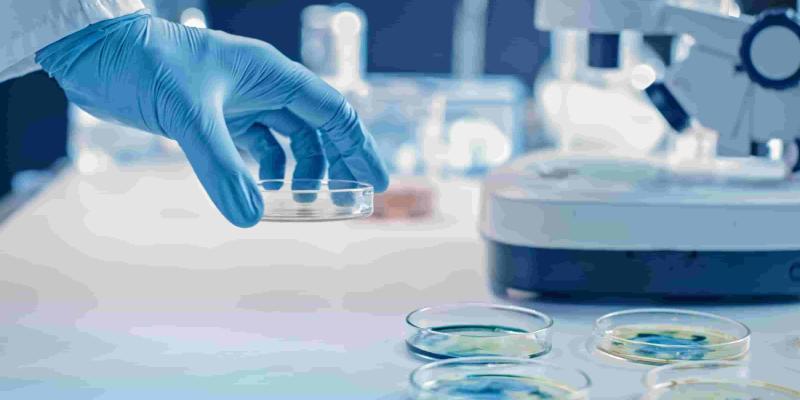
Descubrimiento del gen para las superbacterias

Lectura fácil
Un equipo científico liderado por la Universidad Complutense de Madrid ha identificado un gen, llamado npmA2, que permite a bacterias peligrosas resistir a los antibióticos más potentes. El hallazgo, que ya ha tenido repercusión internacional, supone una alerta global sobre la expansión silenciosa de superbacterias casi imposibles de tratar.
Descubren en España un gen que anula los antibióticos más potentes
Un equipo de investigadores, liderado por la Universidad Complutense de Madrid, ha identificado un nuevo gen llamado npmA2, que representa una grave amenaza para la salud pública. Este gen permite a ciertas bacterias hacerse resistentes a los aminoglucósidos, un grupo de antibióticos considerados como última línea de defensa frente a infecciones graves.
El hallazgo sobre estos antibióticos ha sido descrito como un avance clave en la comprensión de la resistencia antimicrobiana, un fenómeno que preocupa desde hace años a la comunidad científica internacional.
La investigación ha sido dirigida por el doctor Bruno González-Zorn, experto en resistencia bacteriana y catedrático de la Universidad Complutense. El estudio ha contado con la colaboración de prestigiosos centros como el Wellcome Sanger Institute (Reino Unido), el Instituto Pasteur (Francia) y equipos de investigación de Países Bajos y Australia.
Según los investigadores, el gen npmA2 tiene la capacidad de extenderse silenciosamente entre bacterias distintas, aumentando el riesgo de generar superbacterias resistentes a casi todos los tratamientos disponibles.
Un gen con historia y con futuro
Aunque fue detectado por primera vez en Japón en el año 2003, el gen pasó desapercibido durante más de una década. No fue hasta hace pocos años que los investigadores decidieron rastrear su rastro genético, descubriendo que había aparecido ya en muestras humanas, animales y ambientales de al menos seis países.
Entre los lugares donde ya se ha detectado se encuentran Alemania, China, Australia, Reino Unido y los Países Bajos. Además, el equipo trabaja actualmente en zonas de África y América Latina para estudiar su posible presencia en entornos donde hay menos capacidad de detección.
Lo más preocupante del npmA2 es su facilidad para moverse entre bacterias, gracias a un fragmento genético móvil. Este fragmento actúa como un "vehículo" que permite al gen integrarse en diferentes especies bacterianas, incluyendo algunas de las más peligrosas en entornos clínicos.
Entre ellas están Clostridioides difficile, causante de infecciones intestinales graves, y Enterococcus faecium, una bacteria hospitalaria con alta tasa de mortalidad.
Un enemigo difícil de combatir
El gen bloquea el punto de acción de los aminoglucósidos, impidiendo que estos antibióticos actúen. Eso deja a los médicos sin opciones efectivas para tratar infecciones que antes eran controlables.
Por el momento, no existen medicamentos ni técnicas clínicas que puedan eliminar el npmA2. Aunque hay herramientas experimentales en desarrollo, como las "tijeras moleculares", estas aún están lejos de su uso en hospitales.
Cada año, más de 1,2 millones de personas mueren en el mundo debido a infecciones que ya no responden a los antibióticos. En España, se estima que hay más de 20.000 muertes anuales por esta causa.
Los científicos insisten en que es urgente reducir el uso innecesario de antibióticos y mejorar la vigilancia. Además, subrayan que este problema debe abordarse desde un enfoque global, conocido como One Health, que conecta la salud humana, animal y ambiental.



Añadir nuevo comentario